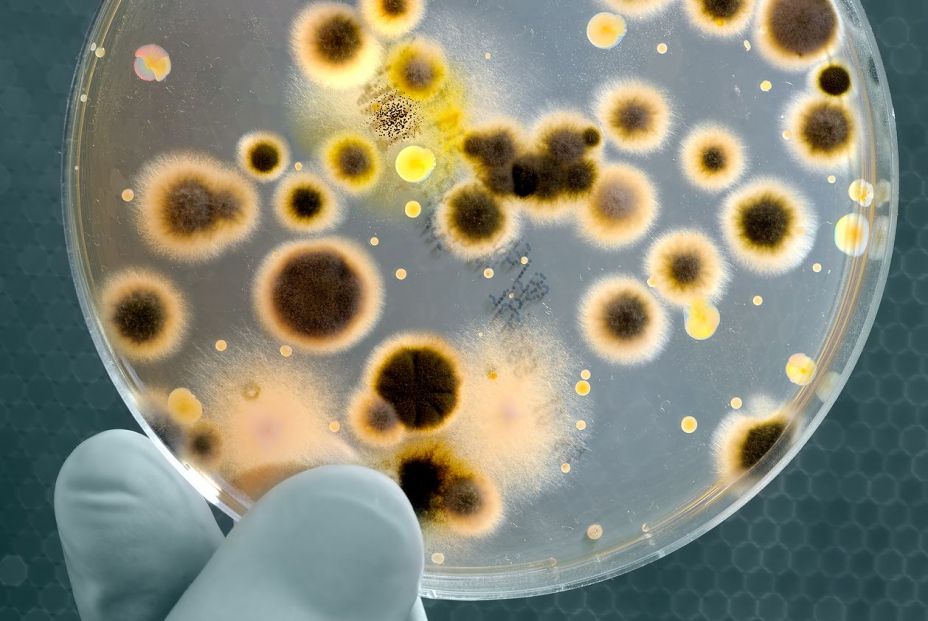
Las bacterias resistentes a los antibióticos ya provocan más muertes que el sida y la malaria Las bacterias resistentes a los antibióticos ya provocan más muertes que el sida y la malaria

La nueva vacuna experimental contra la malaria ofrece buenos resultados en lactantes
Actualmente, hay solo una vacuna contra esta enfermedad aprobada por la OMS
La vacuna contra la malaria está más cerca de convertirse en realidad. Hace unos días, se publicaba un ensayo clínico publicado en la revista Med, donde aseguran que la vacuna parece segura y favorece la respuesta inmunitaria en lactantes africanos, uno de los grupos más vulnerables a la malaria grave.
En la actualidad sólo existe una vacuna contra la malaria, RTS,S, aprobada por la Organización Mundial de la Salud y que ofrece una protección parcial contra la enfermedad. Sin embargo, en los resultados del ensayo de fase Ib realizado en Tanzania han descubierto que dirigirse a la RH5 --una proteína que el patógeno de la malaria 'Plasmodium falciparum' utiliza para invadir los glóbulos rojos-- puede generar una prometedora respuesta inmunitaria que es más pronunciada en una cohorte de lactantes.
"Para prevenir la enfermedad, las vacunas antiesporozoíticas como RTS,S deben ser 100% eficaces para impedir que el parásito invada el hígado", explica Angela Minassian, autora principal y científica clínica de la Universidad de Oxford (Reino Unido).
"Aunque un solo parásito se cuele en la red, se multiplicará en el hígado, pasará al torrente sanguíneo e infectará los glóbulos rojos, donde crecerá a un ritmo exponencial --prosigue--. Contar con una vacuna contra la fase hematógena como la RH5 proporciona una segunda línea de defensa una vez que el parásito ha entrado en el torrente sanguíneo, lo que permite una segunda oportunidad para detener la malaria antes de que cause la enfermedad".
Una persona se infecta de paludismo cuando le pica un mosquito infectado, que libera 'Plasmodium falciparum' en el organismo. RTS,S y muchas otras vacunas candidatas enseñan al sistema inmunitario a atacar al parásito en esta fase de esporozoito, antes de que invada el hígado.
Una vez que el parásito madura y se libera del hígado al torrente sanguíneo, 'Plasmodium falciparum' despliega el RH5 e infecta los glóbulos rojos, lo que causa la enfermedad. Si en el futuro se utilizara una vacuna antiesporozoito y otra anti-RH5 combinadas, los individuos podrían experimentar una protección más eficaz contra la malaria durante un periodo de tiempo más largo.
"Los datos del ensayo de fase 1b del que aquí se informa confirman, por primera vez, que se pueden conseguir respuestas inmunitarias anti-RH5 sustanciales de forma segura mediante la vacunación en lactantes de una zona donde la malaria es endémica", afirman los autores.
Los investigadores realizaron el ensayo de la vacuna en Bagamoyo (Tanzania), donde la prevalencia media del paludismo en toda la población es del 13%. Se inscribieron 63 participantes de edades comprendidas entre los 6 meses y los 35 años, que fueron asignados al azar para recibir la vacuna experimental contra el paludismo, denominada 'ChAd63-MVA RH5', o una vacuna antirrábica de control.
El ensayo también fue doble ciego, lo que significa que ni los participantes ni los administradores de la vacuna sabían quién recibía la vacuna antipalúdica o la de control. A todos los participantes se les administró la segunda dosis de la vacuna dos meses después y se les hizo un seguimiento durante cuatro meses más.
El objetivo principal de este estudio era evaluar la seguridad de esta vacuna en una población donde la malaria es endémica. Los participantes, tanto del grupo de control como del de tratamiento, manifestaron dolor en el lugar de la inyección y fiebre leve poco después de la vacunación, pero en general la vacuna fue bien tolerada y no hubo problemas de seguridad.
Un resultado secundario del estudio era si la vacuna promovería una respuesta inmunitaria. Los investigadores descubrieron que los participantes que recibieron la vacuna contra la malaria desarrollaron anticuerpos contra la RH5 en su sangre durante el seguimiento.
En el laboratorio, estos anticuerpos fueron capaces de inhibir el crecimiento del parásito de la malaria a niveles elevados que se asocian con la protección frente a la enfermedad.
"Estos datos justifican el paso a ensayos de eficacia de campo de fase IIb para determinar si unos niveles de inhibición del crecimiento del parásito de esta magnitud pueden proteger en última instancia contra el paludismo clínico", afirman.
Los autores señalan que observaron las respuestas inmunitarias más fuertes en los lactantes menores de 11 meses, seguidos de los niños de 1 a 6 años y luego los adultos.
"Queda por entender por qué los lactantes y niños pequeños vacunados con ChAd63-MVA RH5 indujeron niveles tan altos de anticuerpos -- apuntan--. Dado que las estrategias de vacunación contra el esporozoito y contra el estadio hematopoyético de la malaria requieren niveles muy altos de anticuerpos para proteger contra la infección parasitaria, los esfuerzos actuales siguen centrados en los lactantes y los niños pequeños".
Los investigadores señalan que se trata de un estudio pequeño en el que se realizó un seguimiento de los participantes durante sólo cuatro meses después de recibir el esquema completo de vacunación. Recomiendan que se lleven a cabo ensayos adicionales de fase Ia/Ib para optimizar el intervalo de edad recomendado, el calendario de refuerzos y la plataforma de administración de las vacunas anti-RH5.
En la actualidad, está previsto realizar un ensayo de fase 1b en Gambia en el que se estudiarán los efectos de la combinación de vacunas anti-RH5 y anti-RH5.